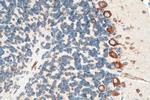
FARSB Antibody in Immunohistochemistry (Paraffin) (IHC (P))

Search
Proteintech
FARSB Monoclonal Antibody (1H10C2)
{{$productOrderCtrl.translations['antibody.pdp.commerceCard.promotion.promotions']}}
{{$productOrderCtrl.translations['antibody.pdp.commerceCard.promotion.viewpromo']}}
{{$productOrderCtrl.translations['antibody.pdp.commerceCard.promotion.promocode']}}: {{promo.promoCode}} {{promo.promoTitle}} {{promo.promoDescription}}. {{$productOrderCtrl.translations['antibody.pdp.commerceCard.promotion.learnmore']}}
产品信息
67924-1-IG150UL
种属反应
宿主/亚型
分类
类型
克隆号
偶联物
形式
浓度
规格
纯化类型
保存液
内含物
保存条件
运输条件
靶标信息
This gene encodes a highly conserved enzyme that belongs to the aminoacyl-tRNA synthetase class IIc subfamily. This enzyme comprises the regulatory beta subunits that form a tetramer with two catalytic alpha subunits. In the presence of ATP, this tetramer is responsible for attaching L-phenylalanine to the terminal adenosine of the appropriate tRNA. A pseudogene located on chromosome 10 has been identified.
仅用于科研。不用于诊断过程。未经明确授权不得转售。
篇参考文献 (0)
生物信息学
蛋白别名: aminoacyl-tRNA synthetase; ph; phenylalanine tRNA ligase 1, beta, cytoplasmic; phenylalanine tRNA synthetase alpha; phenylalanine--tRNA ligase beta chain; Phenylalanine--tRNA ligase beta subunit; phenylalanine-tRNA ligase beta chain; phenylalanine-tRNA synthetase-like, beta subunit; phenylalanyl-tRNA synthetase beta chain; Phenylalanyl-tRNA synthetase beta subunit; phenylalanyl-tRNA synthetase-like, beta subunit; PheRS; PheRS alpha; unnamed protein product
基因别名: C76708; Farsa; FARSB; Farsl; FARSLB; FRSB; HSPC173; NEDBLLA; PheHB; PheRS; RILDBC; RILDBC1; RJBS
UniProt ID: (Human) Q9NSD9, (Mouse) Q9WUA2
Entrez Gene ID: (Human) 10056, (Mouse) 23874, (Rat) 301544